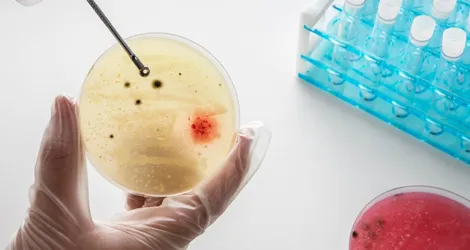

Overview
Leukemia includes all forms of neoplasm affecting tissues that nurture blood, e.g. bone marrow, and damage the immune system. The different types of leukemia depend on how fast they run for the acute lymphoblastic, acute myeloblastic and chronic lymphocytic leukemias.
In these forms, there may be some years without significant symptoms. Acute forms, however, have signs such as long-continued moderate fever, loss of weight, and bleeding, with increased bruising.
The treatment strategy for leukemia depends on its type and how severe it is. People will usually be monitored for slow progression under active surveillance with little or no medical therapy, but cases of acute illness will usually undergo some intensive therapy with chemotherapy, possibly with adjunctive radiation therapy and stem cell transplantation.
This classification divides leukemia depending on the blood cell and the eventual speed with which the abnormal cells proliferate and spread. Acute leukemias appear rapidly and require immediate blood transfusion, while chronic ones are slow, progressive diseases with minimal symptomatology.
The classification has also provided subtypes of leukemia attacking either lymphocytes (type of white cell found in our blood) or myeloid cells (immature cells from which white blood cells, red blood cells, and platelets develop). Such classification is relevant to the treatment implications and prognosis.
Acute lymphocytic leukemia (ALL):
Fastest growing, and most likely seen in children.Acute myeloid leukemia (AML):
Fastest growing and mostly in adult humans.Chronic lymphocytic leukemia (CLL):
Slow-growing type; mostly happens to elderly adults.Chronic myeloid leukemia (CML):
Another slow-growing type but that sometimes can show rates of growth comparable to those seen in CLL.
Risk Factors
Factors That May Increase Your Risks of Developing Some Forms of Leukemia:
Prior treatment for cancer:
Those who have received chemotherapy and radiation therapy of any sort for another kind of cancer may have an increased risk of developing certain types of leukemia.Genetic aberrations:
The genetic anomalies seem to be related to the pathogenesis of leukemia. Such genetic anomalies as Down sickness are responsible for heightened risk for developing leukemia.Chemical:
Some chemical agents are known to be linked to certain forms of leukemia, benzene being one of them; this is a fraction of the component in gasoline.Cigarette smoking:
Cigarette smoking has been shown to increase risks for acute myelogenous leukemia.Family history of leukemia:
If there were people suffering from leukemia in your family, the risk of getting the disease could be increased.
Most people with known risk factors do not develop leukemia. Conversely, many people with leukemia have no known risk factors.
Symptoms
What are the Symptoms of Leukemia Cancer?
The symptoms, in part, depend on the type of leukemia. A chronic form may not display significant symptoms or signs in the early stage. Common signs and symptoms of leukemia may include the following:
- Fatigue, easy tired.
- Fever or night sweats.
- Frequent bouts of infection.
- Shortness of breath.
- Paleness of skin.
- Unexplained weight loss.
- Bone or joint pain, tenderness.
- Left side abdominal pain or fullness.
- Bruising and bleeding including nosebleeds
- Swollen lymph nodes in neck, underarm, groin or stomach, an enlarged spleen or liver.